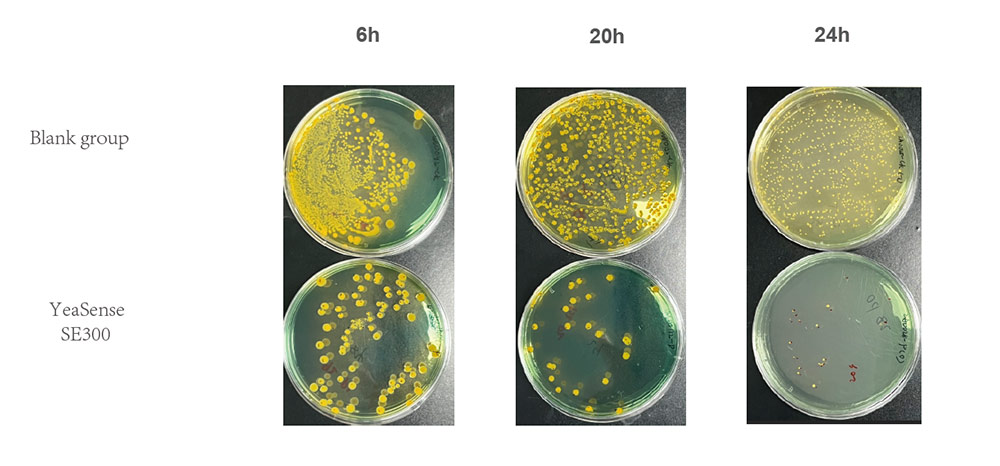
60384870d7f8b1a2

Vibrio is one of the major pathogenic bacteria threatening the shrimp aquaculture industry. Highly pathogenic Vibrio parahaemolyticus and Vibrio harveyi can induce diseases such as Acute Hepatopancreatic Necrosis Disease (AHPND) in shrimp, resulting in massive mortality of post-larvae. In some outbreak cases, the mortality rate can exceed 80%. According to research, Vibrio-related diseases account for more than 40% of the total annual shrimp disease incidence (Liu et al., 2023), and their transmission is closely associated with environmental stress and stocking density. Currently, the aquaculture industry relies on antibiotics for prevention and control. However, the dissemination of antibiotic resistance genes in Vibrio has diminished the efficacy of various drugs, and there is still a lack of efficient, safe, and large-scale alternative prevention and control schemes.
Yeast Glycoprotein for Vibrio Inhibition
Yeast glycoprotein is a natural antibacterial agent extracted and modified from the cell wall of Saccharomyces cerevisiae, mainly composed of covalently linked glucan and mannan. As a green feed additive, it is safe for cultured animals, can specifically stimulate intestinal immunity, inhibit the growth of Vibrio, and leave no chemical residues.
Yeast is the only industrial microorganism with an annual output exceeding one million tons. Yeast glycoprotein is widely distributed in the cell wall of Saccharomyces cerevisiae, representing an abundant resource. Due to its excellent adsorption capacity, antibacterial activity and stability, it has become one of the potential alternatives to antibiotics.Over the past two decades, numerous studies have confirmed that it can enhance disease resistance and reduce Vibrio counts in aquatic animals such as shrimp and fish. However, achieving large-scale, stable production of high-purity yeast glycoprotein, as well as accurately evaluating its application schemes under different culture conditions, remain key challenges for industrialization. At present, biotechnology companies (including Angel Yeast) have developed commercial products using proprietary technologies and applied them in the field of aquaculture.
How Does Yeast Glycoprotein Work?
Yeast glycoprotein inhibits bacteria through a multi-target synergistic physical mechanism. Acting like a ŌĆ£specialized keyŌĆØ, it first recognizes and binds to specific glycoprotein receptors on bacterial cell walls, directly interfering with normal bacterial metabolism and growth. At the same time, it activates host enzymes such as chitinase and glucanase to degrade bacterial cell walls and disrupt the supramolecular structure of bacterial cell membranes, causing cytoplasmic leakage and ultimately leading to bacterial death. This combined mode of action enables it to effectively inhibit pathogenic bacteria while ensuring animal safety, making it a promising alternative to antibiotics in aquaculture.

Angel has over a decade of experience in yeast deep-processing technology, developing efficient, stable, and sustainable feed additives for diverse animal industries. Our mission is to leverage yeast glycoprotein to reduce unnecessary antibiotic use, protect the health and welfare of aquatic animals, and mitigate the economic impact of diseases on farmers.
YeaSense SE300: A Yeast Glycoprotein Feed Additive for Enhancing Fish Resistance Against Vibrio Infections
YeaSense SE300 is a natural immunostimulant derived from the cell wall of Saccharomyces cerevisiae, with glucan-mannan complex as its primary component. It gently regulates fish immunity through a multi-target mode of action: on one hand, it specifically recognizes and binds to the surface of intestinal pathogenic bacteria (e.g., Vibrio), interfering with their colonization; on the other hand, it activates immune cells such as fish macrophages and promotes the balance of beneficial intestinal flora. Prior to feeding, mix it with feed at the recommended dosage to ensure continuous intake by fish. As a naturally degradable substance, this product leaves no chemical residues and requires no withdrawal period, making it safe for both fish and the aquaculture water environment. It has been proven effective in various aquaculture models including shrimp and tilapia, and is suitable for production systems such as ponds and intensive recirculating aquaculture systems (RAS).
Shrimp Field Trial Results
YeaSense SE300 is registered in China and currently marketed as a feed additive. Field trials have shown that application of this product can reduce the number of pathogenic Vibrio in the water (Figure 1), help enhance animal immunity and lower the risk of disease.
Figure 1 pathogenic Vibrio in the
Test animals: Litopenaeus vannamei; initial weight: 18.56 ┬▒ 0.38 g. The number of Vibrio in water was measured at 0 h, 20 h and 24 h, respectively.
In a controlled study (Figure 2), shrimp administered with YeaSense SE300 before bacterial challenge showed a 35.87% increase in survival rate, which was 22.58% higher than the group treated with antibiotics.
Figure 2 Shrimp Survival Rate

Test animals: Litopenaeus vannamei; initial weight: 2.54 ┬▒ 0.10 g; Test period: 48 h treatment of Litopenaeus vannamei infected with Vibrio parahaemolyticus; Stocking density: 90 individuals per group;Dosage: 1500 g/t YeaSense SE300.
In the aquaculture industry, we have developed YeaSense SE3000 to enhance shrimp resistance against Vibrio, reduce losses caused by Vibrio parahaemolyticus and other Vibrio species in shrimp production. This tailored solution will improve farmers' aquaculture profitability.
About Angel Animal Nutrition
Angel Animal Nutrition focuses on providing professional yeast solutions for animal nutrition, caring for animal health, reducing antibiotic use, and promoting the sustainable development of the livestock industry. Together with our partners, we are always in action, working hand in hand to create a better future.
About Angel
Angel Yeast Company is a high-tech listed company specializing in yeast and biotech. Product business covers Yeast and Baking, Yeast Extract-Savoury, Nutrition & Health and Biotechnology fields. It is one of the world's leading companies in the yeast industry. Angel has 12 holding subsidiaries and provides products and services for more than 150 countries and regions.
Press Contact
ANGEL YEAST CO.,LTD
Address: 168 Chengdong Avenue, Yichang, Hubei 443003, P. R.China
Tel:+86-717-6369520, 6369558
Email: aie@angelyeast.com







